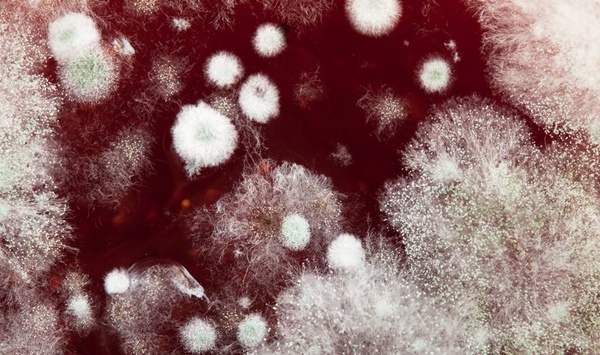

Ung thư là "kẻ thù" lớn nhất của sức khỏe chúng ta. Đến nay, con người vẫn chưa tìm thấy công nghệ hay thuốc điều trị dứt điểm cho căn bệnh ung thư, chính vì thế nó vẫn là mối đe dọa lớn đến tính mạng của nhân loại.
Theo thống kê, vào năm 2020 ước tính tại Việt Nam có 182.563 ca mắc mới và 122.690 ca tử vong do ung thư. Cứ 100.000 người thì có 159 người chẩn đoán mắc mới ung thư và 106 người tử vong do ung thư.
Bệnh ung thư không phải căn bệnh xuất hiện vì sự "xui xẻo" mà theo nghiên cứu, ung thư phần lớn là kết quả của một quá trình sinh hoạt và ăn uống không lành mạnh, hoặc tiếp xúc thời gian dài với những tác nhân gây ung thư.

Trong đó, aflatoxin là một trong những độc tố gây ung thư dễ gặp nhất trong cuộc sống. Aflatoxin là độc tố được tìm thấy ở nấm mốc. Năm 2017, Cơ quan Nghiên cứu Ung thư Quốc tế (IARC) của Tổ chức Y tế Thế giới đã liệt kê aflatoxin vào danh sách các chất gây ung thư mạnh, độc hơn 68 lần so với asen. Nhiệt độ để có thể tiêu diệt aflatoxin là 280 độ C, chính vì thế phương pháp nấu và chế biến thông thường không thể phá hủy độc tính của chất độc này.
Aflatoxin thường xuất hiện ở 5 vị trí này trong nhà, bạn cần xử lý chúng trước khi quá muộn.
Năm 2017, Cơ quan Nghiên cứu Ung thư Quốc tế (IARC) của Tổ chức Y tế Thế giới đã liệt kê aflatoxin vào danh sách các chất gây ung thư mạnh.
5 thứ trong nhà chứa aflatoxin gây ung thư, độc gấp 68 lần asen
1. Tủ lạnh lâu ngày không được vệ sinh
Tủ lạnh có thể nói là vật dụng ít được vệ sinh nhất trong nhà. Trong khi đây lại là đồ vật có tác dụng bảo quản thức ăn, tiếp xúc với cả đồ tươi, đồ sống, đồ ăn thừa nên nguy cơ chứa vi khuẩn, nấm mốc là rất lớn.
Theo một khảo sát của Đại học Arizona (Mỹ) cho thấy, xác suất phát hiện nấm mốc trong khoang và phần đệm của tủ lạnh là 83%. Mỗi lần mở cửa tủ lạnh, nấm mốc lại càng lan rộng và bành trướng nhiều hơn.

Mặc dù các bào tử nấm mốc không thể sản sinh dưới âm 10 độ trong tủ lạnh, nhưng sức sống của nó lại rất ngoan cường. Bào tử có thể tồn tại ở nhiệt độ âm 50 độ và một khi nhiệt độ tủ lạnh tăng lên, nó lại khôi phục sức sống như thường. Nhất là vi khuẩn salmonella, escherichia coli, listeria...
Tủ lạnh lâu không vệ sinh còn là nơi chứa nhiều thực phẩm đã bị mốc trắng, lên men mùi chua, tất cả thực phẩm đã mốc đều sinh ra độc tố aflatoxin. Để phòng tránh nấm mốc, các bà nội trợ nên giữ thói quen vệ sinh tủ lạnh một tuần một lần.
2. Thớt mốc, đũa mốc
Thớt gỗ, đũa gỗ dùng lâu năm có thể sẽ xuất hiện nhiều nứt nẻ, những vết nứt đó chứa vô vàn các thực phẩm li ti bám vào. Nếu thớt gỗ, đũa gỗ được bảo quản trong môi trường ẩm ướt, kém vệ sinh sẽ dễ hình thành nấm mốc, sản sinh ra độc tố aflatoxin, ảnh hưởng đến sức khỏe gan, thận. Đặc biệt việc đun sôi hay lau rửa bình thường không thể làm sạch aflatoxin. Thớt và đũa gỗ nên được thay mới 6 tháng hoặc 1 năm/lần.
3. Trong đậu phộng, ngô, ngũ cốc và các thực phẩm bị mốc
Hàm lượng tinh bột càng cao thì càng dễ tạo ra aflatoxin sau khi bị nấm mốc. Thường là các loại hạt, ngũ cốc, khoai tây, ngô bị mốc. Các thực phẩm này nếu bị tích trữ lâu trong nhà, bị bảo quản trong môi trường ẩm ướt thì rất dễ bị thối mốc. Sau khi con người tiêu thụ sẽ gây ảnh hưởng xấu đến cơ thể, đặc biệt là làm nặng thêm tình trạng tổn thương gan, nếu ăn lâu ngày có thể làm tăng nguy cơ mắc bệnh ung thư gan.

4. Các góc phòng tắm
Aflatoxin rất thích các môi trường ẩm ướt và nhiệt độ cao, cho nên phòng tắm luôn là địa điểm "yêu thích" của chúng.
Một vài nơi như các góc phòng tắm, khớp gạch, rèm phòng tắm... luôn là nơi chứa đựng nhiều nấm mốc hơn bạn tưởng. Cách tốt nhất để giảm sự phát triển của nấm mốc trong phòng tắm là giữ cho phòng tắm thông thoáng, sạch sẽ, dọn dẹp vệ sinh đều đặn hàng tuần.
5. Trái cây và rau thối
Rau quả thối dù có bán giá rất rẻ cũng không nên mua vì chúng chính là ổ chứa aflatoxin.

Một nghiên cứu của Học viện Y tế Dự phòng Trung Quốc cho thấy: Số lượng vi khuẩn có trong trái cây bị mốc chỉ xuất hiện 10% -50% tại phần bị mốc. Số còn lại sẽ xuất hiện rải rác trong các khu vực trông có vẻ lành lặn. Trong các bộ phận bị mốc của trái cây, vi sinh vật tạo ra độc tố aflatoxin, được biết đến là một chất gây ung thư gan mạnh. Nếu một người giữ thói quen ăn trái cây mốc dễ dẫn tổn thương gan, thậm chí gây ung thư gan.
Theo Nhịp Sống Việt
